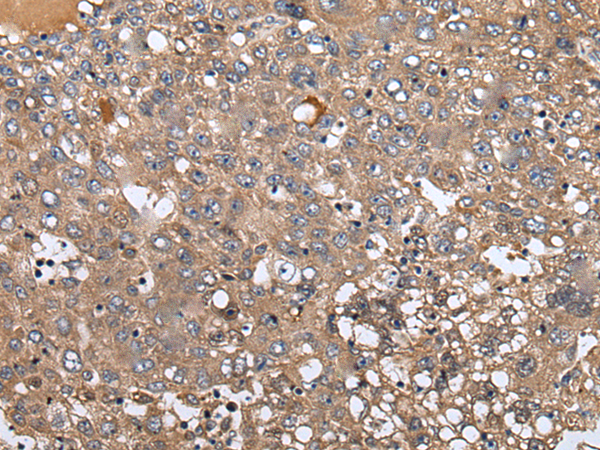

中文名稱:兔抗WIPI2多克隆抗體
|
Background: |
WD40 repeat proteins are key components of many essential biologic functions. They regulate the assembly of multiprotein complexes by presenting a beta-propeller platform for simultaneous and reversible protein-protein interactions. Members of the WIPI subfamily of WD40 repeat proteins, such as WIPI2, have a 7-bladed propeller structure and contain a conserved motif for interaction with phospholipids. |
|
Applications: |
ELISA, WB, IHC |
|
Name of antibody: |
WIPI2 |
|
Immunogen: |
Synthetic peptide of human WIPI2 |
|
Full name: |
WD repeat domain, phosphoinositide interacting 2 |
|
Synonyms: |
Atg21; ATG18B; CGI-50; WIPI-2 |
|
SwissProt: |
Q9Y4P8 |
|
ELISA Recommended dilution: |
5000-10000 |
|
IHC positive control: |
Human liver cancer and human brain |
|
IHC Recommend dilution: |
25-100 |
|
WB Predicted band size: |
49 kDa |
|
WB Positive control: |
Human heart tissue lysate |
|
WB Recommended dilution: |
200-1000 |

購物車
購物車 幫助
幫助
 021-54845833/15800441009
021-54845833/15800441009
